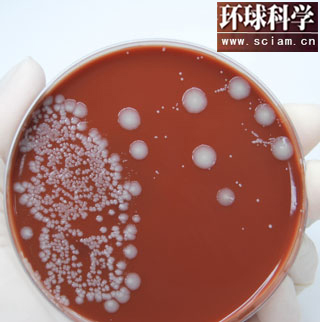

ū½╬─ ┤„ŠSĪżäe┬Õ
┤¾─cŚUŠ·Ģ■ę²░lć└ųžĄ─╩│╬’ųąČŠ░YĀŅŻ¼Ą½═©▀^▀zé„╣ż│╠Ż¼╦³éā┐╔ęį│╔×ķ║▄ėąė├Ą─╦▄┴ŽĪŻ├└ć°╩źĄžüåĖńGenomaticaėąŽ▐╣½╦ŠĄ─┐ŲīW╝ęūŅĮ³ą¹▓╝Ż¼╦¹éā│╔╣”Ąžīó╝ÜŠ·▀Mąą┴╦╠Ä└ĒŻ¼▓óųŲįņ│÷┴╦ČĪČ■┤╝Ż©butanediolŻ¼BDOŻ®ĪŻBDO╩Ūę╗ĘN╗»╣żįŁ┴ŽŻ¼▒╗ė├üĒųŲįņÅ─ÅŚąį└wŠSĄĮ▄ćō§Ą─įSČÓ¢|╬„ĪŻ▓╗ąĶę¬įŁė═║═╠ņ╚╗ÜŌŠ═─▄ųŲįņBDOŻ¼Įo╗»╣żųŲįņśIĦüĒ┴╦Ė³╣Ø─▄Ą─ĘĮĘ©ĪŻ
ėąęµĄ─╝ÜŠ·Ż║▀zé„╣ż│╠┤¾─cŚUŠ·ę▓įS─▄ē“ųŲįņ╦▄┴ŽŻ¼▀@śėŠ═─▄ē“£p╔┘ī”╗»╩»╚╝┴ŽĄ─Ž¹║─
Genomatica╣½╦Šäō╩╝╚╦ų«ę╗Īó¼F╚╬┐é▓├Īó╣ż│╠Ĥ┐╦└’╦╣═ąĘęĪżŽ»┴ųŻ©Christophe SchillingŻ®šfŻ║Ī░╬ęéāī”▀@ą®ėąÖC¾w▀Mąą▀zé„╣ż│╠▓┘ū„Ż¼▀@śė╦³éāĢ■Ęų├┌╬ęéāŽļꬥ─«a╬’üĒ┤┘▀M╔·ķLĪŻūī╬ęéāĖą┼d╚żĄ─ę▓╩Ū▀@ĘNš²Ę┤üÖCųŲŻ║╦³éā╔·ķLĄ├įĮ┐ņŻ¼Ęų├┌Ą─«a╬’Š═įĮČÓĪŻĪ▒╦¹éāį┌2000─Ļ║Y▀x│÷┴╦▀@ĘN╔·«a╬ęéāąĶꬥ─╗»īW╬’┘|Ą─╝ÜŠ·ĪŻ
▀@ą®┤¾─cŚUŠ·─▄ē“į┌░lĮ═╣▐ųą┤¾┴┐╔·ķLŻ©Š═Ž±ė├ė±├ūßäŠŲę╗śėŻ®Ż¼▓óŪę═©▀^▀zé„▓┘ū„Ż¼╩╣╦³éā─▄ē“─═╩▄Ė▀ØŌČ╚BDOĄ─ŁhŠ│ĪŻŽ»┴ųšfŻ║Ī░ūŅķ_╩╝Ż¼║▄Ą═ØŌČ╚Ą─BDOŠ═─▄ē“Üó╦└┤¾─cŚUŠ·ĪŻĄ½¼Fį┌Ż¼╬ęéā╩╣╦³éā▀M╗»Ż¼─▄ē“╔·ķLį┌╬ęéā╦∙ąĶꬥ─ŁhŠ│└’ĪŻ╬ęéāūī╝ÜŠ·į┌╠Ū║═╦«ųą╔·ķLŻ¼üĒųŲįņ╬ęéāŽļꬥ─«a╬’Ż¼╚╗║¾Å─╠Ū╦«ųąīó«a╬’Ęųļx│÷üĒĪŻĪ▒
╚½Ū“ūŅ┤¾Ą─BDO╔·«a╔╠ų«ę╗Ż¼Ą┬ć°╗»īWŠ▐Ņ^░═╦╣Ę“╣½╦ŠŻ©BASFŻ®╔·«aBDO║═Ųõ╦¹╗»īWųŲŲĘĄ─ł╠ąąų„╣▄Ż¼╗»īW╝ę║š▓«╠žĪż░Ż┐╦╦╣╝{Ż©Herbert ExnerŻ®šfŻ║Ī░Ż©╔·«a▀@ą®╗»īWųŲŲĘŻ®ąĶę¬öĄ┴┐┐╔ė^Ą──▄į┤ĪŻĪ▒ę“×ķé„ĮyĄ─BDO╔·«aĘĮ╩ĮąĶꬎ¹║─┤¾┴┐─▄į┤Ż¼Ž»┴ų╝░Ųõ═¼╩┬ė┌╩Ūķ_╩╝ćLįćą┬ĘĮĘ©ĪŻ
┤╦═ŌŻ¼BDOārĖ±įĮüĒįĮ░║┘FŻ¼┼·░lāręčÅ─├┐░§1├└į¬╔ŽØqĄĮ1.22├└į¬ĪŻ░Ż┐╦╦╣╝{šfŻ║Ī░▀^╚źę╗─Ļ└’Ż¼╠ņ╚╗ÜŌ║═╩»ė═Ą─ārĖ±▓╗öÓ╔ŽØqŻ¼Č°╔·«aBDOĄ─įŁ┴Ž▓╗╩Ū╠ņ╚╗ÜŌŠ═╩Ū╩»ė═ĪŻįŁ┴ŽārĖ±╔ŽØq┴╦Ż¼BDOĄ─ārĖ±ūį╚╗Š═Ė·ų°Øq╔Ž╚ź┴╦ĪŻĪ▒
│╔▒ŠøQČ©┴╦ę╗ĘN╦▄┴ŽĄ─╝ė╣ż╔·«aĘĮĘ©─▄ʱ▒╗ÅVĘ║▓╔ė├ĪŻGenomatica╣½╦Š▓ó▓╗┤_Č©▀@ĘNė├┤¾─cŚUŠ·ųŲįņĄ─BDOīó╗©┘MČÓ╔┘│╔▒ŠŻ¼ę“×ķŲ∙Į±×ķų╣Ż¼▀@ĘNĘĮĘ©Č╝▀Ćø]ū▀│÷▀^įć“×╩ęĪŻ
Ą½╩Ūįō╣½╦Š┤_ą┼Ż¼╦¹éāĄ─╔·«aĘĮ╩Į╦∙ąĶ─▄į┤Ż©╝┤╩╣╩Ū░³└©┴╦╩š╝»║═▀\▌öÅ─╩│╠ŪĄĮ└wŠS╦žĄ╚╦∙ėą╬┤╝ė╣żĄ─Įo┴Ž╦∙ąĶĄ──▄į┤Ż®ų╗ąĶę¬32,000ėó¤ßå╬╬╗Ż©British thermal units Ż¼BtusŻ¼1BtusĄ╚ė┌4186.8Į╣Č·)Ż¼ų┴╔┘▒╚é„ĮyĘĮ╩Į╣Ø╩Ī30%Ą──▄į┤ĪŻCEO┐╦└’╦╣═ąĘ“ĪżĖ╩Č„Ż©Christopher GannŻ®šfŻ¼╣½╦ŠėŗäØĪ░ė├▒Ńę╦Ą─ĪóęūĄ├ĄĮĄ─ĪóĘŪ╩│╬’Ą─┐╔│ų└mĮo┴ŽĪŻĪ▒Č°┤¾─cŚUŠ·┐╔ęįį┌│Ż£ž│Żē║Ž┬Ż¼īó▀@ą®Ī░¤oė├Ī▒Ą─╠ŪŅÉūā│╔BDOĪŻČ°é„ĮyĄ─ęį╩»ė═×ķįŁ┴ŽĄ─BDO╔·«aĘĮ╩Į╚¶╩Ū│Ż£žŻ¼Š═▓╗─▄▓╔ė├│Żē║Ż¼Ę┤ų«ęÓ╚╗ĪŻ
Ė╩Č„ča│õĄĮŻ║Ī░─│ę╗╠ņŻ¼įŁė═ārĖ±Ģ■ØqĄĮ├┐═░250├└į¬ę▓▓╗Ųµ╣ųĪŻĪ▒Ų∙Į±×ķų╣Ż¼čąŠ┐╚╦åTų╗╔·«a┴╦▓╗ĄĮ1╣½Į’Ą─BDOĪŻ╦¹Ų┌┤²ę╗éĆą┬Ą─įć“×╣żÅS─▄ē“į┌üĒ─ĻĮ©│╔▓ó═Č╚ļ╩╣ė├ĪŻ
░═╦╣Ę“╣½╦ŠĄ─░Ż┐╦╦╣╝{šfŻ║Ī░╩»ė═║═╠ņ╚╗ÜŌ┐éėąę╗╠ņĢ■Ž¹║─┤∙▒MĪŻĄ½╩Ūų„ꬥ─╣żśIĪ¬Ī¬└²╚ńŲ¹▄ćųŲįņśIĪ¬Ī¬▓ó▓╗Ģ■ę“×ķ─ŃĄ─«aŲĘ╩ŪÅ─╔·╬’īŹ“×╩ę└’│÷üĒĄ─Ż¼Č°Ė╩įĖ╠═Ė³ČÓÕXĪŻĪ▒
¼FļAČ╬ę¬▀_ĄĮ├┐─ĻĢ■╔·«a14ā|Ū¦┐╦ŽÓī”▒Ńę╦Ą─BDOŻ¼Genomatica╣½╦Š╚į╚╗ėą║▄ķLę╗Č╬┬Ęę¬ū▀ĪŻĄ½įō╣½╦Š╠ß│÷Ż¼▀@ĘN▀zé„╣ż│╠┤¾─cŚUŠ·┐╔ęį×ķīóüĒųŲįņ▒žąĶĄ─╦▄┴ŽÅ═║Ž╬’╠ß╣®ę╗ĘN┐╔│ų└mĄ─ĘĮ╩ĮĪŻ
Ė╩Č„šfŻ║Ī░╬ęéā▀xō±Å─ųŲįņBDOķ_╩╝Ż¼╩Ūę“×ķ▀@ĘN╗»║Ž╬’Å─╩»ė═║═╠ņ╚╗ÜŌķ_╩╝ĄĮ│╔ŲĘ╦∙ąĶĄ─▓Į¾EŽÓī”│╔╩ņĪŻČ°╬ęéāęį═┴ĄžĪóĻ¢╣Ō║═╦«ķ_╩╝Ż¼ęį╦«ųąĄ─╠ŪŅÉĮY╩°üĒųŲįņBDOĪŻ╬ęéāūŅ┤¾Ą─ĖéĀÄā×ä▌╩ŪŻ¼▀@╩Ūę╗ĘNĄ═─▄║─Ą─ĪóŁh▒ŻĄ─ųŲįņĘĮ╩ĮĪŻĪ▒Ż©ŁhŪ“┐ŲīWŠÄūg silkŻ®